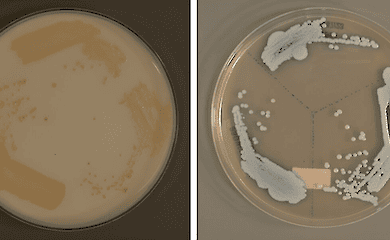
Wissenschaftler in Singapur haben eine neue Art eines tödlichen Pilzes entdeckt

Politico: Wer auch immer US-Präsident wird, die Unterstützung für die Ukraine wird nicht enden
- Startseite
- Politik
- Politico: Wer auch immer US-Präsident wird, die Unterstützung für die Ukraine wird nicht enden


Matthew Kaminski, Gründer von POLITICO Europe und ehemaliger Chefredakteur von POLITICO, schrieb einen Artikel darüber, dass der Sieg von Donald Trump bei den US-Präsidentschaftswahlen nicht das Ende der Unterstützung für die Ukraine bedeuten wird.
Kaminski zufolge gibt es ein Missverständnis darüber, was die US-Präsidentschaftswahl für den schlimmsten Bodenkrieg seit 80 Jahren bedeutet: Der ehemalige Präsident Donald Trump und sein Kandidat JD Vance werden den Konflikt angeblich schnell beenden und die Unterstützung der USA für die Ukraine und die NATO reduzieren, was angeblich katastrophale Folgen haben wird. Kamala Harris wird angeblich die Sprecherin für die Kontinuität der Ära Biden werden und die Ukraine mit umfangreichen Hilfspaketen unterstützen, "so lange es nötig ist", wie ihr derzeitiger Chef sagt.
Wie Kaminski jedoch argumentiert, scheint keines dieser Ergebnisse wahrscheinlich. Ein genauerer Blick auf Trump offenbart eine wohlwollendere Haltung gegenüber der Ukraine. Andererseits wird Harris vielleicht nicht genau in Bidens Fußstapfen treten.
Kaminski stellt fest, dass es in beiden Lagern eine dynamische Debatte gegeben hat. Diese Diskussionen hinter den Kulissen bedeuten, dass sich dieAnsichten und die Politik von Trump und Harris noch weiterentwickeln.
Für die Ukrainer ist dies eine existenzielle Frage. Kaminski betont, dass die Entscheidungen der Amerikaner über die Militärhilfe, die politischen Signale für eine Einigung und die künftige Unterstützung für Kiew die Zukunft des Staates bestimmen werden.
DerUmgang mit der Ukraine wird auch die künftige Außenpolitik der USA auf den Prüfstand stellen und auf die Haltung der nächsten Regierung zur NATO, die Verpflichtungen gegenüber anderen Verbündeten und die Haltung gegenüber einem zunehmend aggressiven China hinweisen. Es steht mehr auf dem Spiel als nur das Schicksal der Ukraine im Jahr 2025.
Kaminski stellt fest, dass sich Harris seit ihrem plötzlichen Aufstieg an die Spitze der Demokraten nicht öffentlich zu ihren Ansichten über die Welt geäußert hat. Für ausländische Beamte und Wähler ist sie ein unbeschriebenes Blatt, auf das sie ihre Hoffnungen und Ängste projizieren können.
Gespräche mit Ukrainern, die dem Präsidenten Wladimir Zelensky nahe stehen, zeigen gemischte Gefühle: Harris ist ein beruhigendes Teammitglied, das sie gut kennen, aber sie wollen auch, dass sie sich vom Biden-Ansatz entfernt, sobald sie im Amt ist.
Kaminski sagt, dass es innerhalb der Demokratischen Partei und zwischen der Biden-Regierung und dem pro-ukrainischen Lager in Washington erhebliche Differenzen gibt. In der Öffentlichkeit loben die Ukrainer und die meisten Demokraten Biden dafür, dass er eine globale Koalition aufgebaut und beispiellose militärische und wirtschaftliche Unterstützung geleistet hat. In privaten Gesprächen sind die Einschätzungen weniger großzügig, und einige ukrainische Beamte äußern Kritik.
Biden war vorsichtig mit Waffenlieferungen, weil er eine Eskalation mit einem atomar bewaffneten Russland befürchtete, was sich nun als übertrieben herausgestellt hat. Diese Vorsicht und Unentschlossenheit hat die Ukraine-Kampagne ins Stocken gebracht und in Kiew für Frustration gesorgt, stellt Kaminski fest.
Die Spannungen erreichten ihren Höhepunkt während des NATO-Gipfels im letzten Monat. Nachdem eine russische Rakete ein Kinderkrankenhaus in Kiew getroffen hatte, lehnte das Weiße Haus die Bitte der Ukraine ab, mit von den USA gelieferten Waffen Raketenabschussbasen in Russland zu treffen. Für Russland hatte dieser Schlag keine Konsequenzen.
Bidens vorsichtiger Ansatz spiegelt die Instinkte seines Teams wider, stellt Kaminski fest. Die Außenpolitik wird von einer kleinen Gruppe langjähriger Berater geleitet, von denen keiner in der Harris-Regierung zu erwarten ist.
Die Ukraine bietet Harris die Gelegenheit, sich subtil von Bidens Politik zu distanzieren, indem sie klarstellt, dass die USA wollen, dass die Ukraine als Siegerin hervorgeht, und dies mit weniger Rüstungsbeschränkungen unterstützt. Harris hat in diesem Sommer an Zelenskys Friedensgipfel in der Schweiz teilgenommen, wo Kaminski sagte, sie unterstütze die strategischen Interessen der Ukraine mit Nachdruck.
Die Alternative zu einer energischeren Unterstützung der Ukraine ist die Akzeptanz der russischen Einflusssphäre, was Amerikas strategische Interessen untergraben würde.
Kaminski stellt fest, dass es auch innerhalb des Trump-Lagers einen internen Kampf um die Außenpolitik gibt. Trump hat in Bezug auf die Ukraine gemischte Signale ausgesandt, so dass alle Seiten ihre Hoffnungen auf ihn projizieren.
Kaminski zufolge hat Trumps "Adieu" zur Wahl von Vance geführt, dem schlimmsten Albtraum der Ukraine. Vance vertritt einen Flügel der Partei, der die Ukraine nicht als Amerikas Problem ansieht. Diese Fraktion würde die Unterstützung für Kiew beenden und Putins Handeln rechtfertigen.
Gleichzeitig hat Trumps Ego einen realpolitischen-internationalen Ansatz gewählt. Seine Regierung bewaffnete die Ukraine 2017 mit Javelins, was sich 2022 als entscheidend erwies, als Putin eine groß angelegte Invasion startete.
Nach der Nominierung von Vance war Trump der erste, der Zelensky anrief. Insidern zufolge verlief das Telefonat gut, wobei Trump versprach, einen gerechten Frieden anzustreben und bestritt, dass er Putin helfen würde, berichtet Kaminski.
Der Anruf war ein Signal an den isolationistischen Flügel der Republikanischen Partei, stellt Kaminski fest. Anfang dieses Jahres unterstützte Trump den Sprecher des Repräsentantenhauses, Mike Johnson, bei der Verabschiedung eines Hilfspakets in Höhe von 60 Milliarden Dollar für die Ukraine.
Zelensky und sein Team haben Verbindungen zu Trumps Verbündeten geknüpft, darunter der ehemalige Chef des Nationalen Sicherheitsrats Robert O'Brien, Außenminister Mike Pompeo und Senator Tom Cotton. Alle drei werden für Posten im Bereich der nationalen Sicherheit in einer möglichen zweiten Trump-Regierung in Betracht gezogen.
Trotz Trumps unvorhersehbarem und transaktionalem Ansatz in der Außenpolitik argumentiert Kaminski, dass sein Sieg im November nicht unbedingt den Untergang der Ukraine oder die Rettung Putins bedeutet. Der Ausgang ist ungewiss und Trumps Team berät noch über seine Position.
Kaminski betont, dass unabhängig davon, wer gewinnt, der nächste Präsident das Engagement der USA in der Ukraine im Sinne der amerikanischen Interessen klar definieren muss.
Ein Frieden mit den von China und Russland angestrebten Einflusssphären würde Amerika wirtschaftlich und strategisch schaden. Dieses Argument spricht dafür, die Ukraine zu bewaffnen, damit sie, und nicht amerikanische Soldaten, diesen Krieg führen, schreibt Kaminski.
Zbigniew Brzezinski sagte einmal: "Ohne die Ukraine hört Russland auf, ein Imperium zu sein." Radek Sikorski aktualisierte dies und sagte: "Russland kann entweder ein Verbündeter des Westens oder ein Vasall Chinas sein. Putin hat sich für Letzteres entschieden."
Ein Sieg der Ukraine bedeutet einen souveränen Staat mit einer Sicherheitsgarantie der USA. Trump und Harris können tun, was Biden nicht getan hat: diesen Sieg definieren und den Platz der Ukraine in der westlichen Welt sichern, glaubt Kaminski.
- Zelensky reagierte auf die Kritik von Trump an ihm
- US-Präsident ordnete einen globalen Zoll von 10 Prozent für alle Länder an
- Medienberichten zufolge besteht aufgrund von Trumps Position ein hohes Risiko, dass die Verhandlungen scheitern
- Trump hat eine Erklärung zu seiner dritten Amtszeit als Präsident abgegeben
- Wie und wann die politische Polarisierung in den USA zunahm
- Trump versprach gute Nachrichten, um Russlands Krieg gegen die Ukraine zu beenden

Eugenia Ruban schreibt über politische und wirtschaftliche Nachrichten. Sie betrachtet die großen Phänomene in der ukrainischen Politik und Wirtschaft aus der Perspektive, wie sie sich auf die einfachen Ukrainer auswirken werden.